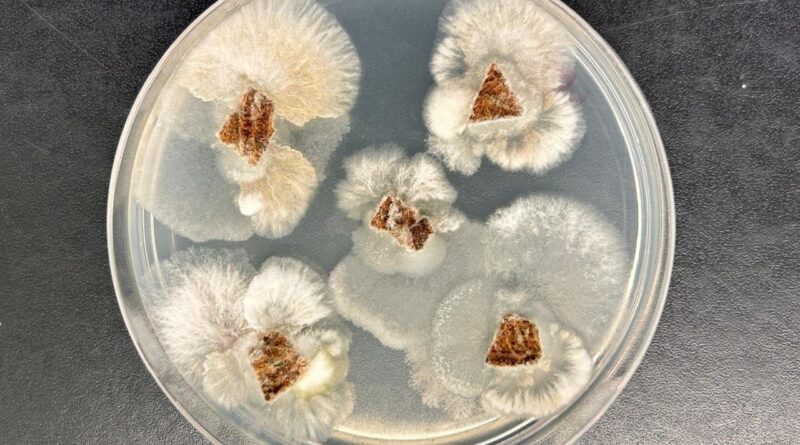
Fungo brasileiro produz substância mais potente que glifosato, aponta estudo

Fungo brasileiro produz substância mais potente que glifosato, aponta estudo

Pesquisadores brasileiros e norte-americanos identificaram uma molécula natural capaz de superar o desempenho de pesticidas tradicionais. O composto foi produzido por um fungo encontrado em uma planta tropical e mostrou alto potencial para o desenvolvimento de bioinsumos agrícolas mais eficientes e sustentáveis.
Uma equipe da Universidade Federal de Minas Gerais (UFMG), da Embrapa Meio Ambiente e do Departamento de Agricultura dos Estados Unidos (USDA) analisou um fungo endofítico isolado de uma planta medicinal tropical do gênero Piper. Esses microrganismos vivem dentro dos tecidos vegetais sem causar danos. Em muitos casos, atuam como aliados naturais das plantas.
O fungo estudado pertence ao gênero Fusarium e foi coletado no Parque Estadual da Floresta do Rio Doce, em Minas Gerais. A partir dele, os cientistas identificaram três metabólitos (substâncias químicas produzidas durante o metabolismo de um organismo) com ação herbicida e antifúngica. Entre eles estava um composto nunca descrito antes na literatura científica.
O novo metabólito, chamado de “composto 2”, apresentou resultados superiores aos de herbicidas sintéticos como glifosato e clomazona. Os testes mostraram que pequenas concentrações foram suficientes para inibir a germinação de plantas daninhas e reduzir o crescimento de espécies usadas em bioensaios.
Molécula natural supera produtos químicos convencionais
Os ensaios ocorreram com sementes de alface e grama-de-bent, modelos amplamente usados pela indústria. Em ambos os testes, o composto impediu o desenvolvimento das plantas. A performance foi comparável ou superior à dos químicos usados como referência.
O composto também se destacou no controle do fungo Colletotrichum fragariae, patógeno que afeta várias culturas. A molécula formou zonas de inibição maiores que fungicidas naturais conhecidos, como carvacrol e timol.
Segundo a pesquisadora Sonia Queiroz, da Embrapa Meio Ambiente, o resultado reforça o potencial dos micro-organismos endofíticos. Eles podem gerar soluções eficazes e com menor impacto ambiental. Ela destaca que o setor busca alternativas devido ao avanço da resistência de pragas e aos limites ambientais impostos pelo uso de químicos tradicionais.
Biodiversidade brasileira impulsiona inovação
A descoberta mostra como a biodiversidade brasileira pode gerar moléculas inéditas com aplicação prática na agricultura. O professor Luiz Henrique Rosa, da UFMG, lembra que os endófitos ainda são pouco explorados. Ele destaca que esses microrganismos funcionam como verdadeiras fábricas naturais de compostos bioativos.
Para a agricultura, o achado tem peso estratégico. O uso de bioinsumos cresce em várias regiões do mundo e responde à demanda por defensivos mais seguros, eficientes e sustentáveis.
Próximos passos para transformar a molécula em produto
Os cientistas afirmam que novas etapas são necessárias. Entre elas estão estudos de segurança ambiental, testes de toxicidade e análises detalhadas dos mecanismos de ação. O desempenho em condições reais de lavoura também será avaliado.
Além disso, os pesquisadores observaram um fenômeno chamado hormese. Em doses muito baixas, o composto estimulou o crescimento vegetal. Esse efeito pode abrir novas aplicações no futuro.
Mesmo sem a identificação completa da espécie do fungo, a caracterização genética permitiu avançar com segurança nos testes. O artigo foi assinado por pesquisadores da UFMG, USDA e Embrapa Meio Ambiente.
Caminho aberto para defensivos mais sustentáveis
Os resultados reforçam o papel estratégico do Brasil na pesquisa de bioinsumos. A biodiversidade nacional pode gerar moléculas capazes de reduzir a dependência de químicos sintéticos e ampliar a eficiência no controle de pragas.
Os cientistas acreditam que o estudo marca o início de uma nova linha de pesquisa. Se confirmado em etapas futuras, o composto poderá integrar herbicidas e fungicidas de nova geração.